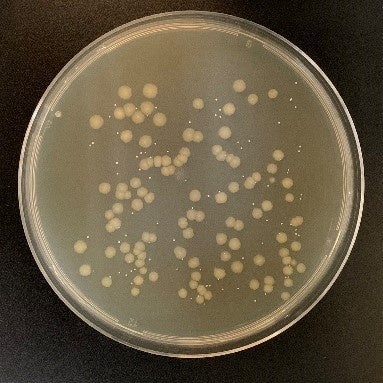
菌付着直後のタオルに付着した菌
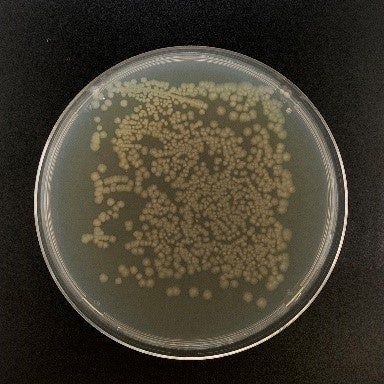
18時間後のタオルに付着した菌

タオルに関する実態調査 タオルの買い替え頻度は1年が最多
一方10人に1人は3年以上使用している ~タオルの寿命を決める3大要素は「見た目」「手触り」「におい」~
※洗濯回数200回の目安…1枚のタオルを週2回使用した場合約2年、週4回使用した場合約1年。
今回、菌やウイルスが気になり始める秋冬に向け、全国の20代~40代の子どもがいる女性500人を対象に、「タオルに関する実態調査」を行いました。
調査結果サマリー

①約8割の人がタオルの雑菌やウイルスが気になると回答 ②タオルの買い替え頻度は1年が最多 一方10人に1人は3年以上使用している ③タオルの寿命を決める3大要素は 「見た目」「手触り」「におい」 ④タオルのにおい対策 1位「柔軟剤」2位「天日干し」3位「酸素系漂白剤」 8割以上の人が何らかのにおい対策を行っている ⑤ 過半数の人がタオルの部屋干しをしている |
<調査結果>
① 約8割の人がタオルの雑菌やウイルスが気になると回答
タオルの雑菌やウイルスについて、約8割の人が「気になる」「少し気になる」と回答しており、タオルへの雑菌やウイルスの付着について関心が高いことがわかります。
タオルの雑菌やウイルスに対して気になりますか?(単回答選択式)n=500

② タオルの買い替え頻度は1年が最多 一方10人に1人は3年以上使用している
バスタオルや手拭きタオルなどの毎日使うタオルの買い替え頻度は、「1年」が最も多い結果となりました。次いで「6か月」、「3か月」となっています。一方、3年以上使っている人も約1割いることがわかりました。
毎日使うタオル(バスタオルや手拭きタオルなど)をどれくらいの頻度で買い替えますか?
(単回答選択式)n=273(※)
※買い替えの頻度が分からないと回答した人を除く

③ タオルの寿命を決める3大要素 「見た目」「手触り」「におい」
タオルを買い換えようと思うきっかけの1位は「見た目の劣化(色褪せ・黄ばみ・破れなど)」(55%)で、「手触りが悪くなる(ごわごわする)」(43%)、「においが気になる」(38%)が続きました。タオルの寿命を決める3大要素が「見た目」「手触り」「におい」であることが窺えます。
タオルを買い換えようと思うきっかけは何ですか?(複数回答選択式)n=500

④ タオルのにおい対策
1位「柔軟剤」2位「天日干し」3位「酸素系漂白剤」
8割以上の人が何らかのにおい対策を行っている
タオルのにおい対策で行っていることの1位は「柔軟剤」(46%)で、2位が「天日干し」(40%)、3位が「酸素系漂白剤を使用」(29%)でした。「特に何もやっていない」(19%)を除くと、8割以上の人が何らかのにおい対策を行っていることがわかります。
タオルの匂い対策で行っていることは何ですか?(複数回答選択式)n=500

➄ 過半数の人がタオルの部屋干しをしている
タオルの部屋干しについて尋ねたところ、6割の人が行っていると回答しています。雨や乾きにくい季節はもちろん、晴れていても、花粉や黄砂、PM2.5など、外に干すことを躊躇う、アレルギーなどで外に出せないなどの要因もあるのかもしれません。
【調査概要】
○調査対象:全国の20代~40代の子どもがいる女性500名(有効回答数)
○調査期間:2023年9月6日
○調査方法:インターネットアンケート
○調査機関:自社調べ(株式会社クロス・マーケティング QiQUMO利用)
タオルは部屋干ししていますか?(単回答選択式)n=500

<タオルの寿命や雑菌、におい対策について>
■タオルにはたくさんの雑菌
タオルの菌の増殖要因には、皮脂(汚れ)、水分、温度、pHなどがあります。菌にはそれぞれ適した生育条件がありますが、その中で最適な条件が揃ってしまうと菌もより増殖しやすくなります。例えば、湿度が高い環境であったり、濡れたままで放置される、何日も同じタオルを使用するなどです。
下の写真は、タオルに菌を付着させ、18時間後に菌の数を計測したものです。一般的なタオルでは、菌付着後18時間で菌の数が増殖していることがわかります。
※一般財団法人日本繊維製品品質技術センター 神戸試験センターによる検査
菌付着直後のタオルに付着した菌
菌付着直後のタオルに付着した菌
18時間後のタオルに付着した菌
18時間後のタオルに付着した菌
■タオルの部屋干し臭の原因は菌
臭い(悪臭)の原因のひとつに細菌の増殖があります。人の肌や粘膜などにはたくさんの菌が存在しており、その中の一部の菌がタオルに残った水分や皮脂などを栄養にして増殖します。タオルの生乾き臭は、「モラクセラ菌」という菌の糞が主な原因ですが、タオルが乾くまでの時間が長いほど菌が増殖しやすいため、湿度の高い時季やこもりやすい場所(部屋干し)で乾燥をする際は注意が必要です。
こういった菌の増殖を防ぐためには、ご家庭では下記のような対策を行う事により、菌の増殖に起因した臭いの発生を予防することが出来ます。
・洗濯乾燥機の使用(コインランドリーの高温乾燥機だとベター)
・熱湯に浸す(ただし、お湯から取り出したら、すぐに洗濯、乾燥)
・漂白剤を使用
・抗菌タオルを使用
■タオルの寿命について
タオルの寿命は、素材や洗い方によっても異なってきますが、交換時期の目安があります。
・タオル自体が薄くなってきた
・タオルのパイルがゴワゴワと硬くなってきた
・色褪せたり変色してきた
・洗っても臭いが残るようになってきた
・パイルの引きつれがいろいろな箇所で発生したり、ヘムがほつれてきた。
これらがタオルの交換時期のサインです。タオルが硬くなれば、拭いた際に肌へのダメージの原因となりますし、臭いが残る場合には菌や菌の排泄物が蓄積している可能性が高く衛生的にあまりいいとはいえません。上記のようなサインがみえたら、新しいタオルに交換して、気持ちも新たに爽快な気分で日々を過ごして頂きたいと思っています。
 <解説者プロフィール>
<解説者プロフィール>
KBツヅキ株式会社 常務取締役 営業本部 第二営業部 部長
髙﨑 俊郎
大学卒業後、大手総合アパレルにて勤務。生産管理の現場での経験を経て、百貨店を中心とするマーケティングで同社最高の売上を記録。その後ライセンス事業部長として数々の海外トップブランドの日本誘致に成功。国内外の著名デザイナー・メゾンとの実績を積む。その後、繊維メーカーにて役員を務め、原料買い付け、紡績工程、生地、製品前の一貫した管理、販売に従事。グローバルブランドとの共同開発など、日本の高い技術力を活かしたヒット商品を多く生み出す。また、経済産業省クールジャパンプロジェクト委員として若手デザイナー支援や、地域繊維産業の活性化をリードした。2022年より現職。
<MAMORUNEについて>

MAMORUNEは、毎日使うタオルを通して、毎日の健やかな暮らしを守りたいという想いから開発された「抗菌タオル」です。抗菌効果が長続きするのが特徴で、菌の増殖を防ぎ清潔を保つことができるので、ご愛用いただいている間ずっと清潔。毎日安心してお使いいただけます。防災用として備えていただいたり、キャンプ用品として使用するのもおすすめです。

好みの使い心地に合わせ、「MAMORUNE STANDARD」「MAMORUNE PURETOUCH」「MAMORUNE POINT TOUCH」の3種類からお選びいただけます。

● MAMORUNE 4つのこだわり ・200回以上洗濯しても抗菌効果が持続 生乾き臭が発生しない ・200回以上洗濯しても柔らかさと吸水性をキープ ・350もの有害物質残留試験をクリア ・SDGsに配慮したタオル |
詳細はこちらの商品リリースをご確認ください
https://prtimes.jp/main/html/rd/p/000000004.000125272.html
公式サイトTSUZUKI COTTON LABO https://tsuzuki-cotton.com
KBツヅキについて
半世紀にわたり、綿花の輸入から紡績、染色整理加工まで一貫して生産する紡績メーカー。タオル糸の原料となる綿花は世界中の生産地から輸入しており、生産地の天気や季節によって状態が異なる綿花を「ブレンド」することで、いつでも高品質を保っています。紡績メーカーだからこそのタオル糸へのこだわりが、KBツヅキの高機能タオルを支えています。国内唯一のタオル用を主とした綿糸生産工場「出雲工場」(島根県出雲市)を有しています。全国の繊維産地に綿糸を提供しており、今治タオル向け綿糸出荷量は国内トップ(2020年今治タオル工業組合「今治地区綿糸受渡数量」より計算)となっています。

公式ホームページ:http://www.tsuzukibo.co.jp/
社名:KBツヅキ株式会社
代表取締役社長:武内 貞継
本社:愛知県名古屋市中区栄3-11-31
設立:1973年9月
資本金:8,000万円
事業内容:衣料用及び工業用繊維製品の生産・加工・販売
このプレスリリースには、メディア関係者向けの情報があります
メディアユーザー登録を行うと、企業担当者の連絡先や、イベント・記者会見の情報など様々な特記情報を閲覧できます。※内容はプレスリリースにより異なります。
すべての画像
